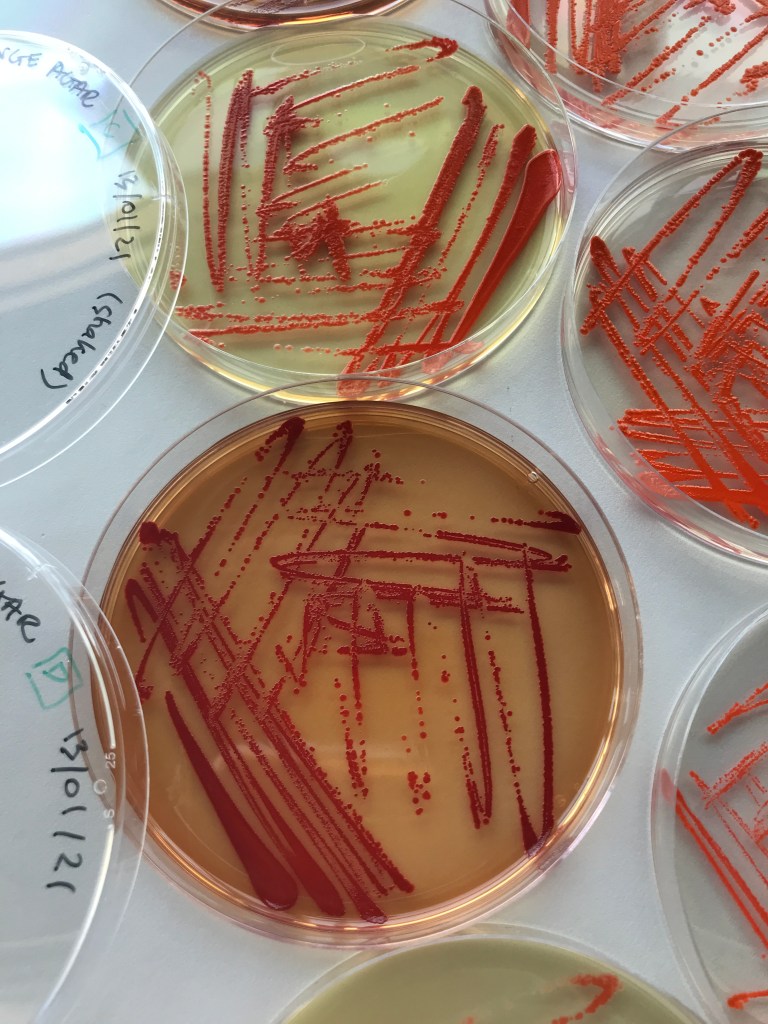
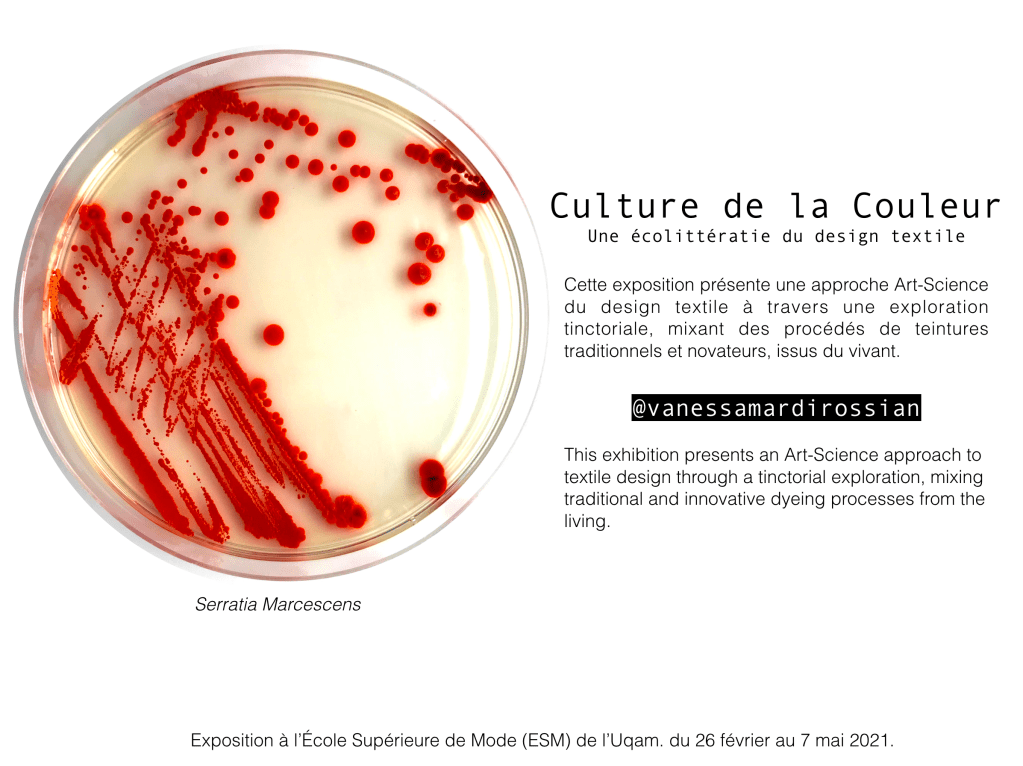
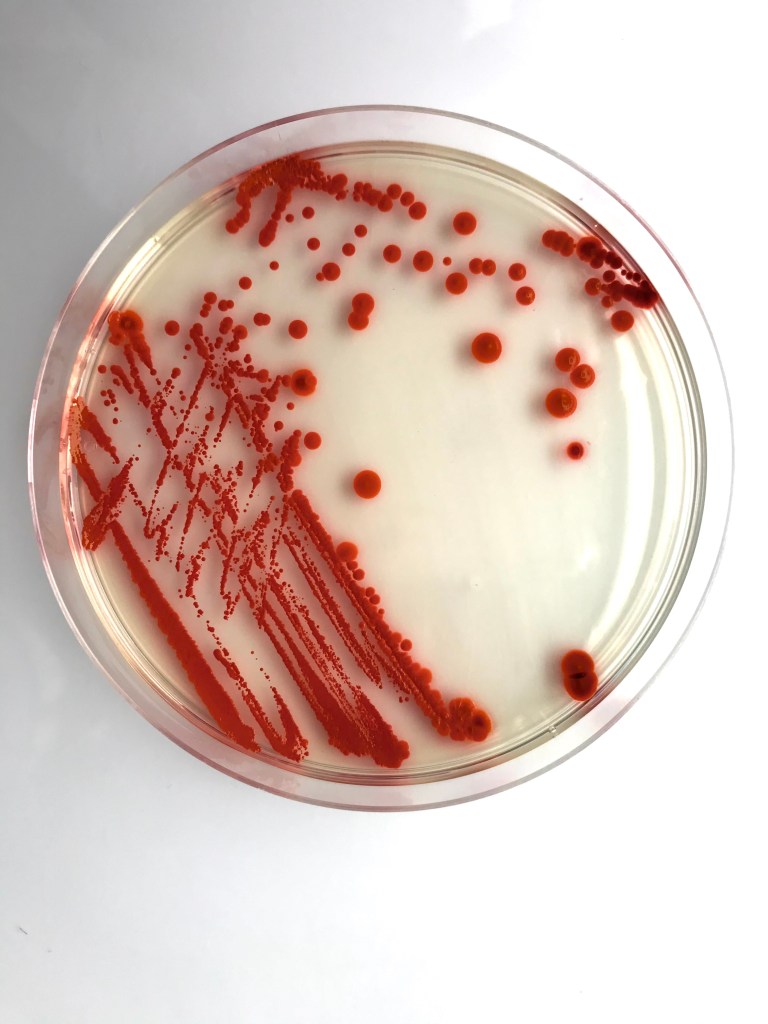
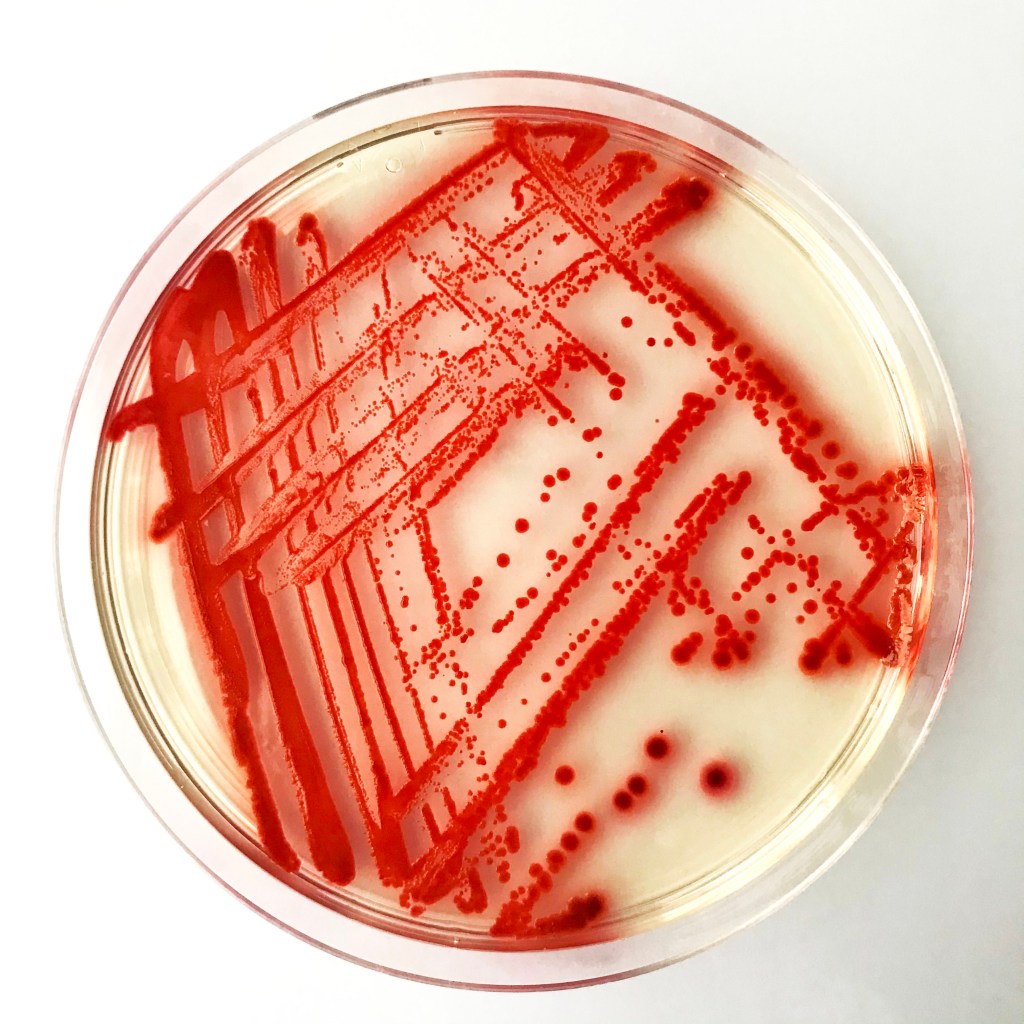

Cluster member Vanessa Mardirossian will be presenting her exhibition, Culture de la couleur: Une écollitératie du design textile, at the École Supérieure de Mode (ESM) de l’UQAM. The exhibition will present an Art/Science approach to textile design through a tinctorial exploration, mixing traditional and innovative dyeing techniques.
Where: The window display of the École Supérieure de Mode (ESM) de l’UQAM – 280 Sainte-Catherine East
When: From the 26th of February until the 7th of May, 2021
You can follow Vanessa’s process on her Instagram: @vanessamardirossian.